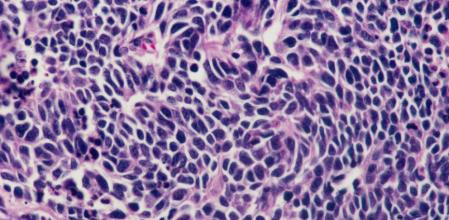
Células cancerígenas de pulmón.

Susan Sontag no quería morir. Le tenía pánico a la muerte. Y durante 30 años vendió su alma al diablo para intentar escapar de las estadísticas. En los años setenta, cuando tenía 43, le diagnosticaron el primer cáncer, de mama, que se diseminó por el sistema linfático. Aunque los médicos le dieron muy pocas esperanzas, sobrevivió. Entonces escribió 'La enfermedad y sus metáforas', un libro en el que esta ensayista norteamericana describía los tumores como un “embarazo demoniaco” y afirmaba “este bulto está vivo”, como si se tratara de un feto al que atribuía voluntad propia.
Dos décadas más tarde padeció otro cáncer, un sarcoma de útero. “Hay algunos supervivientes incluso de los peores cánceres, ¿por qué no iba a ser yo una de ellos?”, solía repetir la escritora, premiada con el Príncipe de Asturias de las letras. Y volvió a salvar la vida. Hasta que apareció el tercero, en el 2004, un síndrome mielodisplásico, antesala de la leucemia mieloide aguda. “¡Pero eso significa que voy a morir!”, cuenta su hijo, David Rieff, que su madre aulló tras escuchar el diagnóstico.
Desafortunadamente, la historia de Susan Sontag tal vez les resulte familiar. Casi todos conocemos a alguien que ha padecido cáncer, un término que engloba un conjunto de enfermedades que son tan antiguas como la propia vida y que afectan a todos los seres que habitan el planeta, desde los reptiles hasta los mamíferos o las aves; e incluso algunas plantas desarrollan nódulos o tumores, conocidos como agallas.
El último estudio publicado por la Agencia Internacional para la Investigación del Cáncer (IARC), un organismo dependiente de la Organización Mundial de la Salud, señala que sólo en un año, el 2012, hubo 14,1 millones de nuevos casos de cáncer en el mundo, murieron 8,2 millones de personas debido a la enfermedad y 32,6 millones estaban en tratamiento.
Pese a que la estadística asusta, los expertos reiteran que “dos de cada tres cánceres se curan o, al menos, se cronifican; en algunos tipos de tumores, la curación es prácticamente del 100%, mientras que en otros, como los de páncreas, podemos hacer mucho menos”, explica Joan Massagué. Sabe bien de qué habla. Este investigador catalán, director científico del hospital Memorial Sloan Kettering de Nueva York (EE.UU.) Y cofundador y aún estrechamente vinculado al Institut de Recerca Biomèdica de Barcelona (IRB), es una autoridad mundial por sus aportaciones para la compresión de los mecanismos moleculares del cáncer y de las metástasis.
“Es cierto que cada vez hay más incidencia de la enfermedad, pero se debe a que vivimos más años y el cáncer está asociado al envejecimiento. Además, también se diagnostican más casos gracias a la tecnología avanzada de que disponemos y a que la gente se hace muchas más revisiones. Antes una persona que tal vez tuviera un pequeño tumor en algún lugar de su cuerpo hubiera muerto de viejo o de otra enfermedad. Hoy se detecta ese pequeño tumor y se trata”, señala Massagué en las dependencias del IRB en el Parc Científic de Barcelona, al que se desplaza cada trimestre y donde comparte con Joan Guinovart visión científica y estratégica.
Cuando se empezó a combatir la enfermedad, hace unos 40 años, los avances científicos del momento sumados al hecho de que se estaba erradicando algunas patologías infecciosas generaron tal vez expectativas poco realistas. Se creyó que la curación del cáncer estaba al alcance. Sin embargo, entonces no se podía ni llegar a imaginar la complejidad de la enfermedad. No se sabía nada acerca de su biología ni que existían unos 200 tipos de tumores.
“Encontrar una especie de penicilina que funcione contra todos los tumores no es posible, y es irreal pensar que algún día daremos con un tratamiento general. Pero vamos entendiendo cuáles son los procesos comunes que las células cancerígenas necesitan para acabar siendo un cáncer mortal. Algún día entenderemos la dolencia del todo y conseguiremos controlar la mayoría de los cánceres”, asegura Antoni Ribas, oncólogo español que dirige el programa de inmunología de los tumores en la Universidad de California-Los Ángeles.
El quid de la cuestión pasa por desarrollar herramientas y estrategias apropiadas en cada caso para combatir cada tipo de cáncer. Durante varias décadas, la medicina ha apostado por desarrollar fármacos cada vez más específicos y complejos para tratar los tumores. Con ellos, la radioterapia y las intervenciones quirúrgicas, se ha conseguido alargar la vida de muchas personas e incluso se ha logrado que muchos tumores sean superables.
“Los últimos 20 años, la ciencia ha hecho grandes avances en la compresión del cáncer, sobre todo en genómica (la ciencia que estudia la información genética de un organismo)”, afirma María Blasco, directora del Centro Nacional de Investigaciones Oncológicas (CNIO), en Madrid. Se han identificado algunos de los genes que mutan y hacen que las células se comporten de formas extrañas; al estudiarlos se ha podido entender mejor cómo se desarrollan los distintos tipos de cáncer y se ha podido diseñar fármacos que inhiben esas mutaciones.
Un ejemplo de estrategias desarrolladas a partir del conocimiento del genoma del cáncer es la de los ratones avatar, acuñados por el CNIO y que están proporcionando resultados muy esperanzadores en el tratamiento del cáncer. “Contienen replicantes de los tumores de los propios pacientes, de forma que sirven como banco de pruebas donde estudiar el tratamiento personalizado en cada caso según las alteraciones genéticas del tumor. El tratamiento que mejor funcione en los avatares será el que se suministre al paciente”, explica Blasco.
Sin embargo, a pesar de todos los avances, de que en la actualidad se están curando más tumores que nunca y de los tratamientos específicos de que se dispone, fruto de cuatro décadas de investigación, no es suficiente, y sigue habiendo algunos tipos de tumores para los que no funciona ninguna terapia actual. De ahí que equipos de investigadores de todo el mundo estudien y prueben nuevas estrategias. La mayoría son todavía experimentales, pero arrojan algo de esperanza para algunos de los cánceres con peor pronóstico. Magazine ha sintetizado algunas de esas nuevas maneras de enfrentarse al cáncer.
Inmunoterapia: reprogramar las defensas
Desde finales del siglo XIX, se ha intentado usar vacunas y tratamientos para tratar de activar las defensas del cuerpo contra diferentes patologías. Cuando las células del organismo adquieren mutaciones, el sistema inmunitario se encarga de deshacerse de ellas y evitar así que se desarrollen tumores. No obstante, con el tiempo, algunas de esas células cancerígenas consiguen escapar a ese control. ¿Cómo? Pues produciendo una serie de proteínas con las que logran pasar desapercibidas ante las defensas. Es como si se volvieran invisibles; el sistema inmunitario deja de detectarlas y de esta manera, el tumor crece sin amenazas.
“El problema principal con el cáncer es que tenemos un sistema inmunitario que no está diseñado evolutivamente para actuar contra los tumores que se generan en el interior del organismo, sino contra amenazas exteriores”, explica Antoni Ribas en una entrevista telefónica desde Los Ángeles. De ahí, indica, que el sistema inmunitario disponga de una serie de mecanismos o frenos que le impiden actuar contra el propio organismo, “porque de no ser así padeceríamos continuamente enfermedades autoinmunes; y ahora sabemos que el cáncer se esconde detrás de estos frenos y los usa en su ventaja”.
Este investigador ya ha identificado dos de esos frenos, bautizados como CTLA4 y PD1. Este último es capaz de bloquear las células blancas asesinas, unos linfocitos que tienen una capacidad muy específica para liquidar las células tumorales. Y ha conseguido quitar esos frenos mediante un fármaco, MK-3475 o lambrolizumab. En un estudio con 135 pacientes que padecían melanoma –un tipo de tumor de piel sumamente agresivo y hasta hace cuatro años intratable– a los que Ribas trató con este fármaco, “vimos que en un 30% de los enfermos, al quitarles ese freno, daban una buena respuesta contra el tumor y que era duradera –apunta–. Entender los procesos por los que el sistema inmunitario se autorregula nos ha permitido acercarnos a nuevos tratamientos”.
Por el momento, Ribas ha probado esta inmunoterapia contra el melanoma, así como el cáncer de riñón y de pulmón, aunque no obtiene los mismos resultados. “Existe la posibilidad de que no funcione en muchos otros cánceres –explica Ribas–. Lo más probable es que podamos aplicar inmunoterapia en tumores que estén inducidos por agentes cancerígenos, como el sol en el caso del melanoma, o el tabaco en el caso del cáncer de pulmón”. Obedece a que en este tipo de tumores se dan muchas alteraciones genéticas y eso permite que el sistema inmunitario diferencie más fácilmente la célula tumoral de las normales.
Ahora bien, quitarle los frenos al sistema inmunitario también comporta efectos secundarios. Se ha visto que uno de cada cinco enfermos a los que se trata con inmunoterapia desarrolla enfermedades autoinmunes, similares a la colitis ulcerosa, sobre todo cuando se actúa sobre el receptor de proteína CTLA4. “Quitar esos frenos no es inocuo, de ahí la importancia de hacerlo de manera muy controlada”, insiste Ribas.
Un saboteador a bordo
En una metáfora, piense en la célula tumoral como un portaaviones que avanza implacable arrasando todo lo que encuentra a su paso. Cuenta con cañones que van disparando, ataca con su flota de aviones y lanza torpedos. Desde la medicina, se intenta detener el avance de ese buque de distintas maneras: enviando barcos que se acercan y le disparan cañonazos, lo que sería la quimioterapia clásica. Poniendo en la cubierta de esos barcos que combaten el portaaviones francotiradores que apuntan a objetivos concretos, que intentan darle al soldado que manipula los cañones, al capitán... Como hacen los fármacos moleculares dirigidos a dianas específicas del tumor. Sin embargo, ninguna de esas dos estrategias de la medicina parece poder detener a este particular buque en algunos casos, hay que idear otras.
“Dentro de ese portaaviones, en la prisión, hay un saboteador nuestro. Lo que hacen los fármacos epigenéticos en que trabajamos es liberar a ese agente infiltrado, abrirle la puerta de la celda para que pueda salir y apagar el radar del buque, taponar los cañones y evitar que el barco siga avanzando y destruyendo todo a su paso”, explica Manel Esteller, uno de los principales expertos en epigenética (la regulación de los genes) en el mundo e investigador en el Institut d’Investigacions Biomèdiques de Bellvitge (Idibell), en l’Hospitalet de Llobregat. “Con estos fármacos liberamos algo que nos protegerá contra el cáncer y hará todo lo posible porque la célula tumoral no progrese”, añade.
Hace menos de tres décadas se vio que existía una especie de interruptores químicos capaces de regular el genoma, el conjunto de genes. Es como si estos fueran el abecedario, y la epigenética, la gramática y ortografía que orquesta la lengua. Esteller se percató de la importancia de esos interruptores desde el inicio y se dedicó a investigar en este ámbito, que hoy se sabe que es clave para entender todo lo que la genética no puede explicar.
Por el momento, existen cinco fármacos epigenéticos en el mercado, algunos dirigidos a tumores que hasta ahora tenían un pronóstico nefasto, como ciertos tipos de leucemia y de linfoma. Lo que hacen estos medicamentos es actuar sobre la desprogramación del ADN e intentar recuperar una regulación normal de los genes. Para ello, se dirigen contra las proteínas que causan esas alteraciones epigenéticas. “Sin duda, estos fármacos han cambiado la historia de la enfermedad –asegura Esteller–. Gracias a ellos, los pacientes tienen ahora una supervivencia de muchísimos años”.
Están en fase de desarrollo nuevas moléculas que se espera que sean fármacos útiles para sarcomas y neuroblastomas, dos de los tumores pediátricos más frecuentes. “Cada año conseguimos que un 2% más de pacientes se curen, lo que implica que en una década tenemos un 20% más de casos de éxito”, añade Esteller.
Un virus como caballo de Troya
Hace poco más de cuatro años, en el hospital Niño Jesús de Madrid se llevó a cabo un estudio con niños muy pequeños que padecían un neuroblastoma, un tumor del sistema nervioso periférico que puede ser muy agresivo y con una media de supervivencia de entre nueve y doce meses después del diagnóstico. Además de un tratamiento de radioterapia y de quimioterapia, se les inyectó un virus, el del resfriado común, modificado genéticamente para que se replicara sólo dentro de las células tumorales y las destruyera. Los resultados fueron muy dispares: en tres pequeños no funcionó, pero en uno las metástasis que tenía diseminadas por el cuerpo desaparecieron por completo. Los médicos no daban crédito.
Puede que hablar de virus para tratar el cáncer pueda sonar, cuanto menos, a ciencia ficción, pero lo cierto es que es una estrategia prometedora: entre el 10% y el 20% de pacientes terminales reaccionan a ella. En Barcelona, en el Institut Català d’Oncologia (ICO), Ramon Alemany trabaja desde hace años en el diseño de virus capaces de colarse en los tumores y destruirlos. Los modifica genéticamente y entonces los inyecta en el tumor del paciente para que el virus comience a replicarse allí, hasta que la célula acaba explotando; eso libera de nuevo el virus, que infecta nuevas células tumorales, y así, hasta que desaparecen todas o hasta que el sistema inmunitario reacciona contra el virus y, en ocasiones, contra el tumor.
De momento, ya hay en marcha tres ensayos clínicos en el ICO con 20 pacientes afectados por melanoma, cáncer de páncreas y diversos tipos de tumores, sobre todo de metástasis de colón, a los que se inyectará el Icovir5 o VCN01, ambos virus, diseñados por Alemany. “Tratamos a personas que no tienen otra posibilidad de tratamiento. Estas terapias experimentales sólo se ofrecen cuando todo lo demás ha fallado o bien en combinación con quimioterapia cuando esta es muy poco eficaz, como en el caso del cáncer de páncreas –comenta Alemany–. Nuestro reto es llegar a entender por qué a algunas personas les funciona y a otras no”.
En Estados Unidos, en el MD Anderson Cancer Center de Houston, el matrimonio formado por los neurólogos españoles Candelaria Gómez y Juan Fueyo usa otro virus que han diseñado en colaboración con Alemany, el Delta24RGD, que inyectan directamente en el tumor cerebral del paciente. En un ensayo de esta terapia, entre el 10% y el 20% de los enfermos respondieron al tratamiento. Aunque el porcentaje pueda parecer reducido, es en realidad elevado en el tipo de tumores con que trabajan. Gómez y Fueyo prevén que durante este año se inicie un estudio en siete universidades de Estados Unidos para determinar la eficacia del virus Delta24RGD.
En la Clínica Universidad de Navarra, en colaboración con el MD Anderson, se ha iniciado también un ensayo con este virus. “Llevamos diez pacientes tratados y, aunque debemos ser muy cautos, hemos obtenido muy buenas respuestas en algunos de ellos. Puede que un 10% de respuesta parezca poco, pero lo cierto es que hasta ahora quienes padecían un glioblastoma (un tumor cerebral muy agresivo) tenían muy mal pronóstico”, explica la investigadora Marta Alonso, quien se formó en el laboratorio de Gómez y Fueyo en Houston.
Frenar el avance del enemigo
Detrás de los mecanismos que utilizan los tumores para proliferar y colonizar diversos tejidos y órganos se hallan procesos propios de la formación del embrión. Para que se forme un bebé, de una célula fecundada se deben formar 12 trillones de células. Eso les obliga a dividirse a gran velocidad, y además, tienen una gran capacidad de transformarse en cualquier tipo de célula (para formar los distintos tejidos). Pues bien, se ha visto que cuando en un adulto se reactivan unas proteínas, llamadas CPEB, implicadas en esa división celular embrionaria, se crean tumores.
Eso es lo que ha descubierto el investigador madrileño Raúl Méndez, todo un referente en el campo de la regulación génica y que estudia en su laboratorio del Institut de Recerca Biomèdica una nueva estrategia para incidir justamente en esas proteínas y en la proliferación celular.
“Hemos visto que esas proteínas reactivan un patrón embrionario, lo que fomenta que el tumor prolifere de forma descontrolada. Si las quitamos, el tumor pierde la capacidad de proliferar y de desdiferenciarse”, explica Méndez. “El reto que tenemos por delante será conseguir fármacos que inhiban esas proteínas para poder usarlos en clínica, en pacientes”, añade.
El enfoque de Méndez, a priori, debería comportar muchas ventajas. Para empezar, como estas proteínas no se expresan en órganos adultos sanos, estos fármacos deberían tener pocos efectos secundarios. Además, es un tratamiento ultraselectivo y sería una buena alternativa para tumores que han generado ya resistencia.
El mecanismo de la metástasis
Hace apenas tres meses, una noticia sobre el cáncer dio la vuelta al mundo: Joan Massagué había descubierto el mecanismo por el que las células del cáncer de mama y de pulmón se esparcían por el cerebro, es decir, el mecanismo de la metástasis. De poderse bloquear ese mecanismo, se podrían evitar gran parte de las metástasis, la causa de muchas de las muertes por cáncer.
“La persona que ha padecido un tumor, aunque las pruebas den negativo, está sembrada de estas células tumorales, las 'semillas' de la metástasis (que germinarán o no), de la misma manera que cuando pasas una gripe, en tus mucosas sigues teniendo virus de gripe aunque ya no estés enfermo. Desconocemos cómo viven, cómo consiguen salvarse y cómo matar a esas semillas. Y es lo que ahora quiero estudiar”, explica el investigador.
Esas células cancerígenas que se desprenden del tumor viajan por la sangre y se dirigen a otros tejidos. La mayoría mueren, pero otras consiguen aguantar, esconderse y resistir meses e incluso décadas. Y pueden despertar y causar nuevos tumores, lo que llamamos metástasis. “Si entendemos qué ocurre, podremos diseñar fármacos que dejen aisladas esas células y las fuercen a morir. La idea por el momento es futurística, pero para mí es un concepto lo suficientemente potente como para que haya dejado todo el trabajo que hago y piense dedicarme a esto el resto de mi carrera”, apunta Massagué.
Biopsia en la sangre
De los tumores suelen escapar células que circulan por la sangre. Esas células son invisibles para las tecnologías de imagen que se usan para diagnosticar el cáncer. Pero podrían detectarse en la sangre. “En el futuro, esta detección podría servir para rastrear mejor las células madre cancerígenas, las células más inmortales del cáncer, capaces de provocar después la metástasis”, explica Rafael Rosell, jefe del servicio de oncología médica del Institut Català d’Oncologia y uno de los mayores expertos en el mundo en cáncer de pulmón. “En una sola célula tumoral circulante se puede secuenciar todo el genoma del tumor, mirar la expresión de los genes y no sólo las mutaciones, las alteraciones de proteínas. De manera que podamos lograr fármacos más inteligentes”, señala.
La enfermedad en niños
“El cáncer infantil es un conjunto de enfermedades raras que se parecen más a las malformaciones que al tumor de páncreas o de mama de los adultos”, explica el oncólogo pediátrico Jaume Mora, director científico de oncohematología en el hospital Sant Joan de Déu en Esplugues (Barcelona). En adultos, el cáncer está relacionado con la degeneración del cuerpo por el envejecimiento: las células se dividen, acumulan mutaciones, pierden su capacidad de reparación y acaban volviéndose cancerígenas. En cambio, en los niños, adolescentes y adultos jóvenes, está relacionado con el proceso contrario, la generación. “En la formación del embrión, cuando las células se dividen y diferencian, si algo va mal, se producen malformaciones y también cáncer”, explica Mora. Por ejemplo, una célula puede quedar bloqueada en su proceso de maduración. “Esa célula es el origen de los tumores de generación del desarrollo. Preferimos llamar así a la enfermedad porque puedes tener 20 años y padecer uno de estos tumores”, aclara el médico.
Uno de cada 10.000 niños y adolescentes padecerá uno de estos cánceres. Se diagnostica un tumor infantil por cada 100 de mama. Y se calcula que en el 2050, uno de cada 30 adultos será un superviviente de cáncer infantil. El 80% de los pequeños pacientes sobrevive. Hay tipos de tumor que se curan en prácticamente todos los casos, como ciertas leucemias. Otros, no, como son algunos tumores cerebrales, como el glioblastoma o el tumor difuso de tronco o DIPG.
Jaume Mora y su equipo acaban de dar un paso de gigante para hallar una cura para este último tumor. Son de los pocos equipos en Europa que lo biopsian, con lo que han podido encontrar las primeras mutaciones susceptibles de tratamiento con fármacos dirigidos a ellas (lo que se llama dianas). Y han generado el primer modelo animal, un ratón capaz de reproducir la enfermedad. “Eso abre la puerta a estudiar en profundidad este cáncer y encontrar, por fin, una solución”, indica Mora, quien resalta la ayuda de las familias, que consiguen la mayor parte de la financiación para la investigación de estas enfermedades raras.